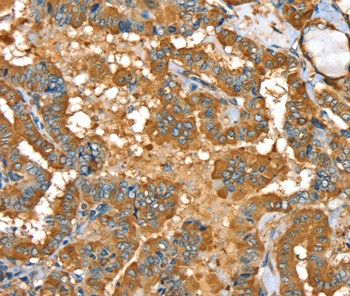
PYGL Antibody in Immunohistochemistry (Paraffin) (IHC (P))

Search
Invitrogen
PYGL Polyclonal Antibody
{{$productOrderCtrl.translations['antibody.pdp.commerceCard.promotion.promotions']}}
{{$productOrderCtrl.translations['antibody.pdp.commerceCard.promotion.viewpromo']}}
{{$productOrderCtrl.translations['antibody.pdp.commerceCard.promotion.promocode']}}: {{promo.promoCode}} {{promo.promoTitle}} {{promo.promoDescription}}. {{$productOrderCtrl.translations['antibody.pdp.commerceCard.promotion.learnmore']}}



Please note: We are reviewing Western blot images included in the antibody testing data in our catalog, including those provided by third parties. Unless expressly labeled or annotated as “raw-unedited”, Western blot images included in the antibody testing data in our catalog may have been edited, optimized or otherwise adjusted for presentation.
产品信息
PA5-50479
种属反应
宿主/亚型
分类
类型
抗原
偶联物
形式
浓度
规格
纯化类型
保存液
内含物
保存条件
运输条件
RRID
产品详细信息
The antibody detects endogenous levels of total PYGL protein.
靶标信息
This gene encodes a homodimeric protein that catalyses the cleavage of alpha-1,4-glucosidic bonds to release glucose-1-phosphate from liver glycogen stores. This protein switches from inactive phosphorylase B to active phosphorylase A by phosphorylation of serine residue 15. Activity of this enzyme is further regulated by multiple allosteric effectors and hormonal controls. Humans have three glycogen phosphorylase genes that encode distinct isozymes that are primarily expressed in liver, brain and muscle, respectively. The liver isozyme serves the glycemic demands of the body in general while the brain and muscle isozymes supply just those tissues. In glycogen storage disease type VI, also known as Hers disease, mutations in liver glycogen phosphorylase inhibit the conversion of glycogen to glucose and results in moderate hypoglycemia, mild ketosis, growth retardation and hepatomegaly. Alternative splicing results in multiple transcript variants encoding different isoforms.
仅用于科研。不用于诊断过程。未经明确授权不得转售。
篇参考文献 (0)
生物信息学
蛋白别名: glycogen liver; Glycogen phosphorylase, liver form; GPLL
基因别名: PYGL
Entrez Gene ID: (Human) 5836